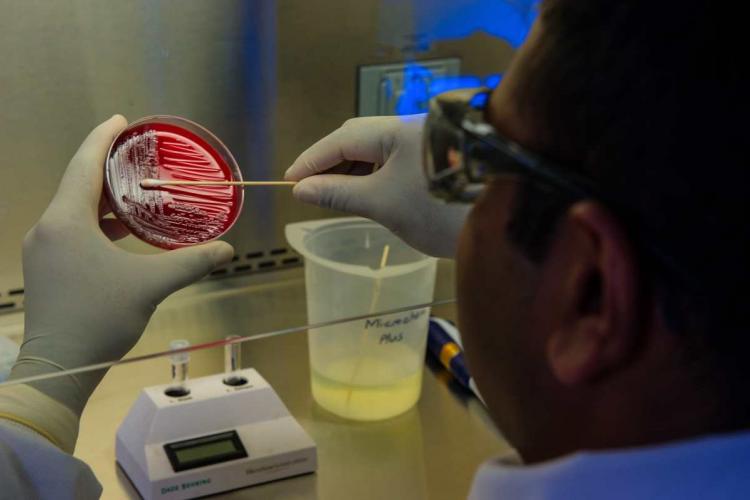

Ξεκινούν από σήμερα τα rapid test στην Αττική από τις κινητές μονάδες του ΕΟΔΥ.
Τα συνεργεία των Κινητών Ομάδων Υγείας του ΕΟΔΥ, βγαίνουν σε χώρους εργασίας και χώρους συναθροίσεων στην Αττική, που βρίσκεται στο επίκεντρο της πανδημίας. Με τον αριθμό κρουσμάτων να έχει εκτοξευθεί στην Αττική, αποφασίστηκε η πραγματοποίηση των rapid test ώστε να σχηματιστεί μια πιο καθαρή εικόνα ως προς τον αριθμό των κρουσμάτων.
Όπως ανακοίνωσε ο υφυπουργός Πολιτικής Προστασίας τα rapid tests θα γίνονται σε χώρους εργασίας και συναθροίσεων στις επιβαρυμένες περιοχές της Αττικής, όπως και σε υπηρεσίες του δημοσίου και του ιδιωτικού τομέα που κρίνονται απαραίτητες για την απρόσκοπτη, συνεχόμενη λειτουργία του κράτους και της οικονομίας (σχολεία, μέσα μαζικής μεταφοράς και -κυρίως- νοσοκομεία).
Πως λειτουργούν τα rapid test
Τα rapid tests, σε αντίθεση με τα μοριακά, ανιχνεύουν το αντιγόνο του ίδιου του ιού, μέσα σε λίγα λεπτά. Μάλιστα, σύμφωνα με τους ειδικούς, η εγκυρότητα του τεστ μπορεί να αγγίζει και το 90%. Τα περισσότερα «γρήγορα τεστ» που κυκλοφορούν δεν ανιχνεύουν τον ιό, αλλά τα αντισώματα που έχει δημιουργήσει ο οργανισμός εναντίον του. Η ανάπτυξη όμως αυτών των αντισωμάτων δεν είναι άμεση. Αρχίζει μερικές ημέρες μετά την έναρξη της νόσου και κορυφώνεται αρκετές εβδομάδες μετά. Ωστόσο, σύμφωνα με τις φαρμακευτικές εταιρείες, το rapid test έχει δύο μεγάλα πλεονεκτήματα έναντι του PCR: Το άμεσο αποτέλεσμα και τη χαμηλότερη τιμή.